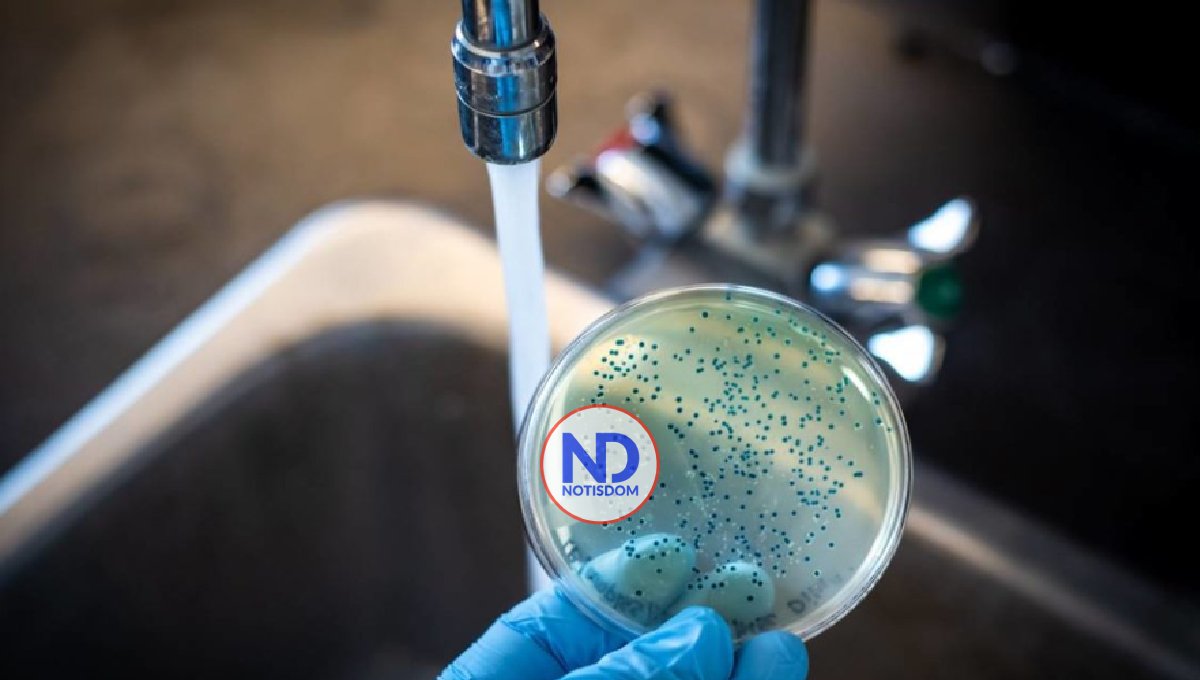
Autoridades informan de tres nuevos casos de cólera en la RD

Autoridades informan de tres nuevos casos de cólera en la RD
SANTO DOMINGO.- El Ministerio de Salud Pública notificó este domingo tres nuevos casos de cólera, dos de ellos de nacionalidad haitiana, y un dominicano residente en la barriada capitalina de Villa Francisca.
Una de las personas haitianas ingresó recientemente el país, dijo el organismo en un comunicado.
Los pacientes fueron evaluados y se les aplicó el tratamiento adecuado entre el 2 y 3 del presente marzo, al presentar diarrea acuosa, pero sin complicaciones debido a que no se encontraban deshidratados, por lo que ya estabilizados fueron enviados a sus hogares para continuar con sus respectivos tratamientos, dijo Salud Pública.
De acuerdo con el reporte epidemiológico hasta el momento no hay familiares de los pacientes con síntomas sospechosos de la enfermedad.
El organismo exhortó a la población «a cuidarse» y acudir «de inmediato» a un centro de salud de presentar evacuaciones diarreicas acuosas varias veces en el día.
El reporte epidemiológico de este domingo indica que no hay personas ingresas a causa de la enfermedad y que «más de 88 personas se han recuperado de manera «satisfactoria».
Salud Pública aseguró que sus diferentes direcciones mantienen los operativos preventivos, de seguimiento y control de casos y la intervención permanente en los sectores identificados para detectar cualquier sospecha o emergencia que pudiere presentarse.



